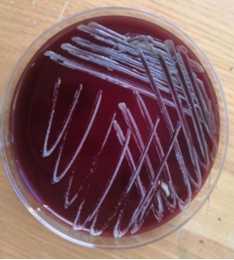

近日,市人民医院接诊了一例“特殊”的患者,患者(女)于20天前不慎摔伤左侧乳房,未行特殊处理,四天后乳房出现红肿、发热、疼痛加剧等症状,于外院治疗效果不佳后转入我院普外一科。经过常规检查后,诊断为左乳腺脓肿,随即将穿刺脓液注入培养瓶后送至微生物室进行检测,同时行乳房脓肿切开引流术。
从接到标本开始,微生物室便与临床医生积极进行沟通,了解患者情况。脓液培养报阳后,立即抽取培养液进行革兰染色镜检,发现有“鬼影”细胞,然后行抗酸染色,结果示阳性。随即转种血平板进行培养,发现有大量分枝杆菌属细菌生长,利用分枝杆菌菌种鉴定基因检测对菌种进行鉴定,最终确定为龟分枝杆菌。在整个检测过程中,微生物室随时与临床沟通,将检测情况即时反馈。临床根据检测结果调整用药,并每日为患者清理伤口脓液,患者病情明显好转。

龟分枝杆菌广泛存在于自然环境中,属条件致病菌,人主要从环境中获得感染,当机体免疫功能障碍时即可导致病变。龟分枝杆菌的精准检测标志着市人民医院微生物实验室成功将非结核分枝杆菌鉴定到种。本次病例中,标本的规范送检、检测结果的精准无误以及临床与实验室的及时沟通无疑为患者的治疗提供了强有力的保障!
标签:胶州市人民医院 左乳腺脓肿 龟分枝杆菌




